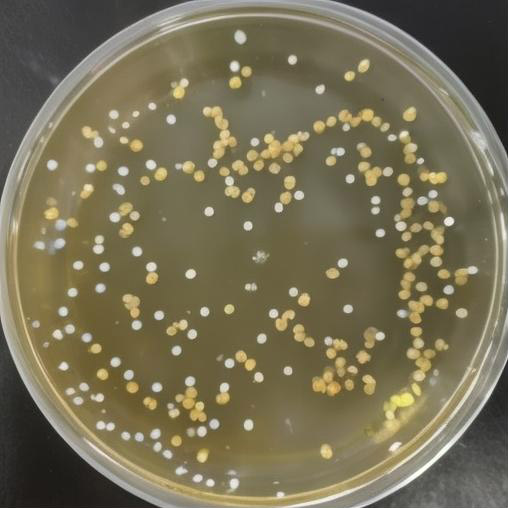

金黄色葡萄球菌(Staphylococcus aureus)是一种常见的革兰氏阳性球菌,因其在培养基上常形成金黄色的菌落而得名。它是一种机会性致病菌,广泛存在于自然界中,如人体皮肤、鼻腔等部位就可能有它的存在,一般情况下与人类共生而不引起疾病。但当机体免疫力下降或菌群失衡时,金黄色葡萄球菌可引起多种感染,包括皮肤软组织感染(如疖、痈)、呼吸道感染、骨骼感染、心内膜炎等,严重时甚至能导致败血症和中毒休克综合征。
金黄色葡萄球菌具有较强的抵抗力,能够产生多种毒素和酶类,如溶血素、凝固酶、肠毒素等,这些毒素不仅有助于细菌侵袭组织,还可能导致食物中毒。此外,某些金黄色葡萄球菌对抗生素具有耐药性,其中耐甲氧西林金黄色葡萄球菌(MRSA)是对甲氧西林及同类抗生素耐药的菌株,治疗更为困难,是医院内感染的重要病原体之一。
预防金黄色葡萄球菌感染的关键在于良好的个人卫生习惯,如勤洗手,正确处理伤口,以及合理使用抗生素以减少耐药性的产生。对于已经感染的患者,需要根据药敏试验结果选择合适的抗生素进行治疗。
文章版权声明



